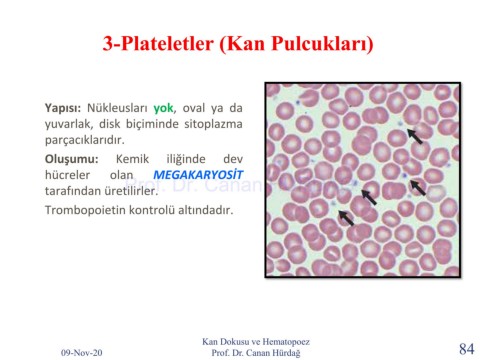

Page 84 - kan dokusu ve hematopoez konu 2020.ppt
P. 84
3-Plateletler (Kan Pulcukları)
Yapısı: Nükleusları yok, oval ya da
yuvarlak, disk biçiminde sitoplazma
parçacıklarıdır.
Oluşumu: Kemik iliğinde dev
hücreler olan MEGAKARYOSİT
Prof. Dr. Canan HURDAG
tarafından üretilirler.
Trombopoietin kontrolü altındadır.
Kan Dokusu ve Hematopoez
09-Nov-20 Prof. Dr. Canan Hürdağ 84